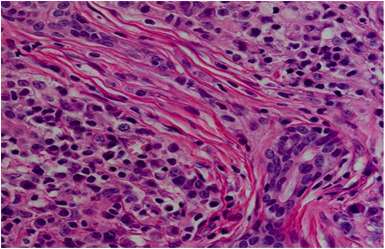
Enfermedad relacionada con inmunoglobulina IG4

Publicado enReumatología
Enfermedad relacionada con inmunoglobulina IG4
La enfermedad relacionada con la inmunoglobulina G4 (IgG4), conocida como "IgG4-related disease" en inglés, es un trastorno sistémico de causa desconocida que se caracteriza por una fibroinflamación altamente característica. Esta…